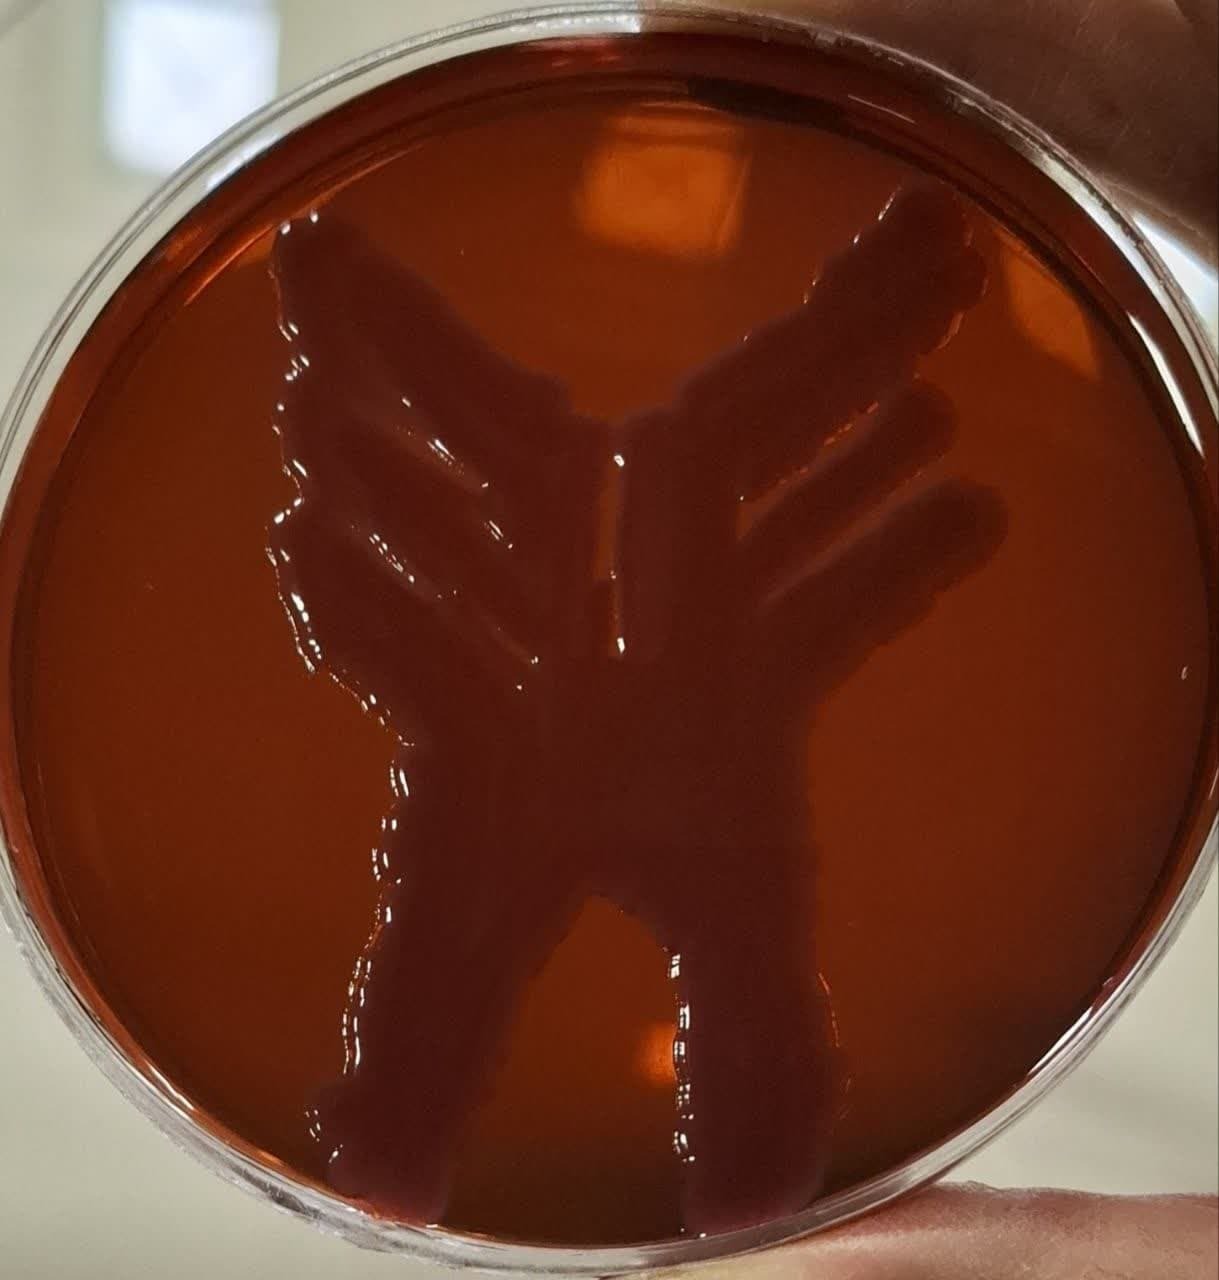
نگاه هفته؛ نگاه هفته؛

از مژدگانی محققان برای بیماران تنفسی تا مدلسازی سازه مقابل زلزله
خبرگزاری آنا؛ روزهای جمعه هر هفته نگاهی به رویدادها، موفقیتها، برنامهها و دستاوردهای علمی دانشگاهیان، پژوهشگران، فناوران، محققان و دانشجویان دانشگاه آزاد اسلامی همراه با بازنشر گفتوگوهای طول هفته با عنوان «نگاه هفته» داریم که در این گزارش میخوانید. (گزارش کامل هر رویداد، گفتوگو، خبر و ... در لینک مربوط (هایپرلینک) قابل مشاهده و مطالعه است)
* خبرنگار آنا برای اطلاع از آخرین وضعیت نهضت مسکن ملی مسکن، مسکن مهر، فناوریهای بهکار گرفته شده در صنعت ساختمان، آخرین وضعیت مسکن هنرمندان و خبرنگاران، بهبود کیفیت مصالح بهکار رفته در تولید مسکن و ... گفتوگویی را با آرش صیادی مدیرعامل شرکت عمران شهر جدید پرند ترتیب داده است تا به بررسی چالشها و دستاوردها پرداخته و چشمانداز آینده صنعت ساخت و ساز در شهر جدید پرند را مورد کنکاش قرار دهد.(گفتوگوی تفصیلی آنا با صیادی)
* الهام نوروزی عضو هیئتعلمی گروه میکروبیولوژی دانشگاه آزاد اسلامی واحد شاهرود در گفتوگو با خبرنگار آنا با اشاره به برگزاری نمایشگاه نقاشی آگار با باکتریها در این واحد دانشگاهی اظهار کرد: این نمایشگاه هنری منحصربهفرد بوده که در آن باکتریها بهعنوان مواد اولیه برای خلق آثار هنری جذاب استفاده میشوند.
* سیدپوریا موسوی دانشجوی هنرمند دانشگاه آزاد اسلامی گفت: موسیقی سنتی ایرانی با لطافت و اصالت خود، پیوندی عمیق با احساسات انسانی برقرار میکند و مسیری برای حفظ هویت هنری است.
* یک شرکت دانشبنیان محصولی بومی و ایرانی دارای قابلیتهای کنترلی پیشرفته با نام «یکسوسازهای سوئیچینگ حفاظت کاتدی» تولید کرده که امکان مانیتورینگ و کنترل از راه دور را مهیا میکند. (گفتوگوی آنا با جواد کلاهدوزان مدیر شرکت)

* فرشید سلیمی رئیس دانشگاه آزاد اسلامی استان اردبیل از انعقاد تفاهمنامه همکاری این دانشگاه با شرکت ملی پخش فرآوردههای نفتی ایران خبر داد و در گفتوگو با خبرنگار آنا اظهار کرد: بهمنظور توسعه زمینههای همکاری مشترک و همه جانبه علمی پژوهشی و فناوری و استفاده بهینه از ظرفیتهای موجود این تفاهمنامه بین دو طرفین منعقد شد.
* رشد روزافزون جمعیت و افزایش جاذبههای گردشگری در سالهای گذشته، شهرها را به محیطهایی شلوغ و پرازدحام تبدیل کردهاند، در این میان، پروژههای شهر هوشمند به عنوان راهکاری نوین به کمک مدیریت خدمات شهری آمدهاند تا تجربهای بهینه را برای گردشگران و ساکنان به ارمغان آورند. (بخش ۲۲ پرونده شتاب علمی؛ پیشروی ایران، رکود غرب)
* مهدی نصری معاون پژوهش و فناوری دانشگاه آزاد اسلامی واحد خمینیشهر با توجه به طراحی و ساخت دستگاه کمک سرفه برای بیماران مبتلا به بیماریهای تنفسی توسط دانشآموخته این دانشگاه به خبرنگار آنا در خمینیشهر گفت: این دستگاه که توسط مهسا گوهرآرا دانشآموخته کارشناسی ارشد رشته مهندسی پزشکی واحد خمینیشهر و کارشناس تجهیزات پزشکی بیمارستان طراحی و تولید شده، قادر است بهویژه برای بیماران مبتلا به بیماریهای مزمن ریوی و آتوفی عضلانی نخاعی (SMA)، نقشی مؤثر در بهبود شرایط تنفسی ایفا کند. (مشروح گفتوگو)
* بهمنظور ارتقای ارتباط و همکاری شهرداری و دانشگاه، هسته تحقیق و توسعه واحد فناور شهرداری مراغه در مرکز رشد دانشگاه آزاد اسلامی راهاندازی میشود و در این راستا ماشین نیمه اتوماتیک جویشور طراحی و ساخته خواهد شد.

* به گزارش خبرنگار آنا، داروخانه آموزشی و تخصصی دانشگاه آزاد اسلامی واحد آیتالله آملی با حضور مسئولان دانشگاهی گشایش یافت. این داروخانه آموزشی با بهرهگیری از مجوز داروخانه دکتر پردیس زابلی راهاندازی و در تفاهمنامه همکاری دانشگاه با دکتر زابلی آغاز به کار کرده است.
* حسین سوادکوهی رئیس مرکز تحقیقات «مواد دندانی، فناوریها و روشهای نوین در دندانپزشکی» گفت: در این مرکز خدمات آزمایشگاهی مانند انواع تستهای مکانیکی مواد دندانی، شبیهساز چرخه حرارتی محیط دهان و تستهای شیمیایی انجام میشود.
* علیرضا صداقت عضو هیئت علمی دانشگاه گفت: انسجام اجتماعی و کاهش نابرابریها جزء جداییناپذیر توسعه پایدار هستند و خدمات اجتماعی با مشارکت دولت، دانشگاه و سازمانهای غیردولتی میتوانند این هدف را محقق کنند. (گفتوگوی تفصیلی آنا با صداقت)
* دانشگاه آزاد اسلامی ایلام و یک گروه صنعتی و پژوهشی با محور پژوهش، فناوری، اشتغالزایی و کارآفرینی تفاهمنامه امضا کردند.
* آرش صالحزاده برگزیده مسابقات ملی مهارت در حوزه فناوری طراحی گرافیک ۳ راهکار کلیدی برای موفقیت نوجوانان در این مسابقات را تشریح کرد.

* نخستین نرمافزار مدلسازی سازه در ایران با هدف ارتقای ایمنی و دقت در طراحی سازهها در برابر زلزله به دست طراحان و توسعهدهندگان داخلی طراحی و تولید شد، این نرمافزار با قابلیتهای خود به مهندسان امکان میدهد تا بر چالشهای موجود در نرمافزار ETABS غلبه کرده و به تحلیل دقیقتری از رفتار سازهها در برابر زلزله دست یابند. (گفتوگوی آنا با داود علیجمشیدی عضو هیئت علمی دانشگاه آزاد اسلامی)
* بزرگترین برج پرچم پهنه جنوب کشور در دانشگاهها به ارتفاع ۳۶ متر همزمان با روز بزرگداشت شهدا رونمایی شد و پرچم ایران در دانشگاه آزاد اسلامی آباده به اهتزاز درآمد.
* مهناز قمی رئیس مرکز تحقیقات مواد اولیه دارویی دانشگاه علوم پزشکی آزاد اسلامی تهران گفت: ارتباط با صنایع داروسازی، عقد تفاهمنامه و قرارداد برای رفع نیاز مشکلات صنایع دارویی و مواد اولیه از مهمترین فعالیتهای جاری این مرکز است.
* به گزارش خبرنگار آنا، در نشست فعالان اقتصادی استان یزد، خیّران با حضور استاندار، مقامات دانشگاهی و صنعتی، مبلغ ۳۵ میلیارد ریال را برای تجهیز بیمارستان تخصصی شاهولی کمک کردند.
* محمدابراهیم سراج مدیرکل دفتر انتصابات و بازرسی ویژه دفاتر نهاد نمایندگی رهبری در دانشگاه آزاد به مناسبت وفات حضرت خدیجه به خبرنگار آنا گفت: نام حضرت خدیجه (س) در قلب تاریخ اسلام بهعنوان همسر پیامبر اکرم (ص) و نخستین زن مسلمان میدرخشد؛ چراکه با فداکاری بینظیر و حمایتهای صادقانهاش از پیامبر (ص)، پایههای دین مبین اسلام را مستحکم کرد. (مشروح گفتوگوی تفصیلی آنا با سراج)

* ناهید دامنپاک مقدم و سیمینسادات وهابزاده مقدم اعضای هیئت علمی دانشگاه آزاد اسلامی واحد تهران جنوب در یادداشتی به مناسبت وفات حضرت خدیجه نوشتند: حضرت خدیجه (س) بعد از ازدواج با حضرت محمد (ص) همه ثروت خود را برای توسعه دین اسلام خرج کرد. پیامبر (ص) همه جا از او به نیکی یاد میکرد و درباره آن حضرت فرمودند: خدیجه وقتی به من پیوست که همه از من دور میشدند. او در راه اسلام، هرگز مرا تنها نگذاشت و همواره از من حمایت کرد. (متن کامل یادداشت)
* دانشگاه آزاد اسلامی واحد اصفهان (خوراسگان) میزبان دانشجویان رشتههای معماری، شهرسازی و هنر در رویداد رقابت استانی «شهر، زندگی، آب» بود که ۲۹۰ اثر دانشجویی به آن ارسال شد.
* مسیب جاوید مهر رئیس باشگاه پژوهشگران جوان و نخبگان دانشگاه آزاد اسلامی همدان عنوان کرد که در یک سال اخیر با رشد چشمگیر فعالیتهای علمی، پژوهشی و مهارتی، جایگاه ویژهای در ارتقای کیفیت آموزشی و مهارت افزایی دانشجویان این دانشگاه ایفا کردهایم. (مشروح گفتوگوی آنا با جاوید مهر)
* انورسادات نایبینیا رئیس مرکز تحقیقات مراقبتهای بالینی و ارتقای سلامت گفت: تجاریسازی نتایج حاصل از پژوهشهای کاربردی در حوزههای مختلف مرتبط با سلامت و توسعه روابط و تعاملات علمی، آموزشی و پژوهشی با سایر مراکز تحقیقاتی و دانشگاهی ازجمله اهداف این مرکز است. (مشروح گفتوگو)
* سیدمسعود داودی عضو هیئت علمی دانشگاه آزاد گفت: بهطور کلی با استفاده از فناوریهای نوین مانند شبکههای هوشمند، ذخیرهسازی انرژی و بهینهسازی طراحی شبکهها، میتوان تلفات انرژی را کاهش داده و پایداری شبکه برق را بهبود بخشید. (گفتوگوی تفصیلی آنا با داودی در شماره ۱۴ پرونده ناترازی انرژی از دریچه علم)

* مجتبی جعفری مدیرکل فرهنگی اجتماعی دانشگاه آزاد استان اصفهان در یادداشتی به مناسبت روز شهید نوشت: خداوند در آیه ۱۷۰ و ۱۷۱ سوره آلعمران حالات شهدا را بیان میکند. شهدا در آن حالات نورانی و فوق تصوری که در آن قرار گرفتهاند به آنچه خداوند از لطف و عنایتش به ایشان داده، شادمانند و بشارت میدهند به کسانی که هنوز به این مقام نائل نشدهاند و به آنان میگویند که در این مقام هیچ ترس و اندوهی برایشان نخواهد بود. (متن یادداشت جعفری)
* حسین اصغری شیوایی رئیس دانشگاه آزاد اسلامی واحد علوم و فناوری پردیس عنوان کرد که یک مرکز تحقیقات و نوآوری مشترک در دانشگاه آزاد با مشارکت صنایع در حوزه هوش مصنوعی به منظور حل چالشها و نیازهای صنعت راهاندازی میشود.
* کورش پارسا معین رئیس دانشگاه آزاد اسلامی واحد دماوند از برگزاری نخستین کنگره (همایش) ملی فناوریهای نوین و تحول صنعت بتن در این دانشگاه خبر داد و جزئیاتی از این همایش را تشریح کرد.
* گردشگری شهری ایران بهعنوان یکی از جاذبههای کمتر شناختهشده و غنی این سرزمین در مواجهه با تحریمها به گنجی پنهان تبدیل شده و در دوران سخت اقتصادی، هر قدم در کوچههای قدیمی و هر نگاه به صنایع دستی محلی، داستانهایی از هنر و فرهنگ را روایت میکند که قابلیت رقابت با برترین نقاط گردشگری جهان را دارد. (قسمت ۲۳ از پرونده شتاب علمی، پیشروی ایران، رکود غرب)
* بهروز بیات معاون دانشگاه آزاد همدان به آنا گفت: این واحد دانشگاهی با هدف توسعه دانش و پژوهشهای کاربردی در حوزه محیط زیست و ارائه راهکارهای علمی برای حل چالشهای زیستمحیطی موفق به جذب دانشجویان پسادکتری در رشته محیط زیست شده است.
* نیمقرن گذشته عرصه کشاورزی ایران را در تحولات شگرفی قرار داده؛ از رشد بهرهوری و افزایش ۲۰۰ درصدی تولید محصولات استراتژیک تا تلاش بیوقفه برای دستیابی به خودکفایی در شرایطی که تحریمها سایه سنگین خود را بر سر کشاورزان ایرانی انداختهاند.(قسمت ۲۴ از پرونده شتاب علمی؛ پیشروی ایران، رکود غرب)

* ناترازی انرژی در شبکههای توزیع برق بهعنوان یکی از چالشهای اساسی در تحقق توسعه پایدار و تأمین انرژی مطمئن در کشورها، بهخصوص ایران مطرح است و با توجه به پیچیدگیهای جغرافیایی، اقتصادی و اجتماعی کشور، شناسایی عوامل مؤثر بر بروز این ناترازی از اهمیت بالایی برخوردار است.(قسمت ۱۵ پرونده ناترازی انرژی از دریچه علم)
انتهای پیام/